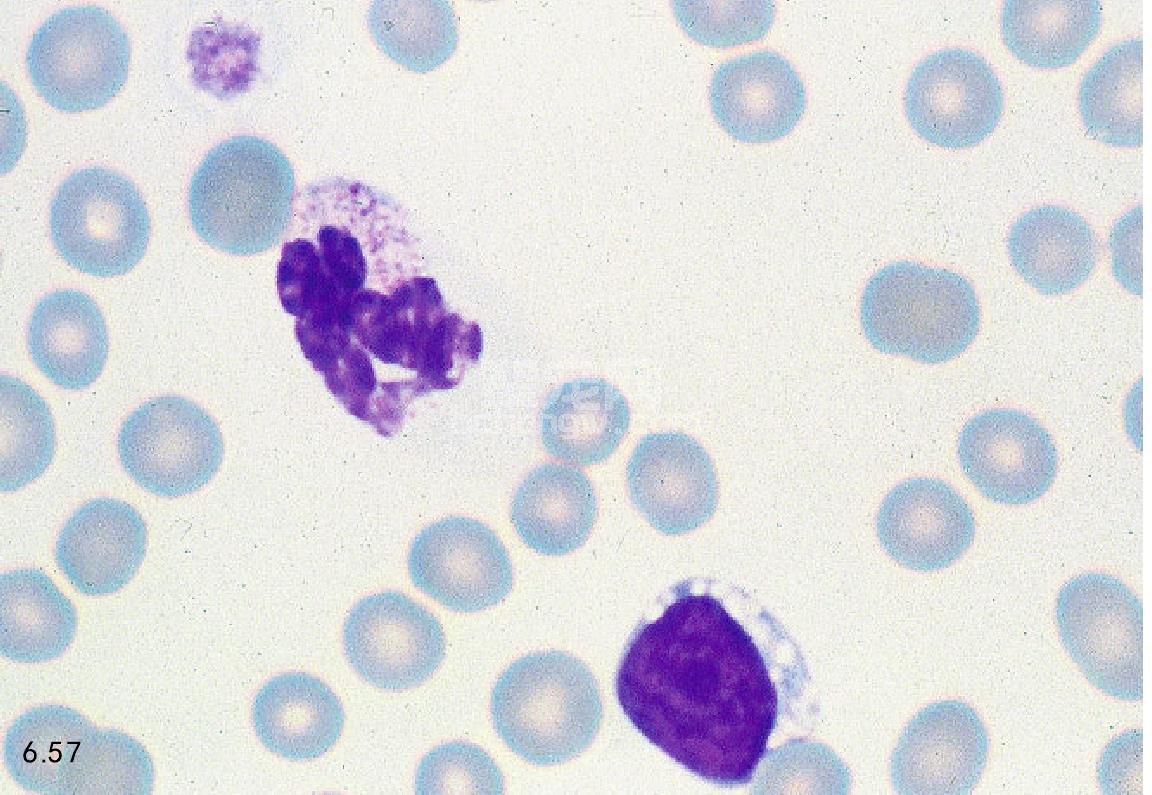

溶酶体贮积症
犬/猫疾病诊断
鉴别诊断 应与加有乙二胺四乙酸的血液贮存时间延长,胞质毒性等疾病相鉴别。
诊断 血象可见损伤的淋巴细胞有多个点状的胞质泡(图6.57)。这些空泡应与加有乙二胺四乙酸的血液贮 存时间延长的假象变化相区别。通过血液和(或)组织酶活力的测定试验可区分这些疾病。
图6.57 猫溶酶体贮积症时的血液涂片:嗜中性白细胞中的胞质颗粒;淋巴细胞的斑块状胞质空泡。
医疗动态
-
医:影响母猪淘汰七大因素!值得收藏
母猪是猪场的核心,母猪繁殖力的高低影响着猪场年断奶仔猪数,决定猪场能否实现出栏目标。为了使生产持续稳定,猪场需要对母猪群进行有计划地更新(淘汰)。 母猪淘汰分为主动(正常)淘汰和被动(异常)淘汰。 主动淘汰是指有计划地对繁殖性能低、胎[详细]
-
医:冬季猪舍氨味重,咳嗽多,这5招轻松搞定!
天气愈渐寒冷,让养猪人非常头疼的问题来了:密闭不好,通风量大,舍内温度降低,轻则会影响猪的生长速度。因为猪要消耗一部分能量来维持自身体温,重则容易流感、应激;密闭严实一点,舍内温度上来了,但是氨气味特别大,猪群非常容易换上呼吸道方面的疾病。[详细]
-
医:猪食盐中毒的症状表现及治疗方法
食盐是猪日粮中不可缺少的成分。按饲料中含食盐量0.3%饲喂猪,可改善食欲,促进发育,但摄入过量常引起食盐中毒。有一位养猪朋友外购了一批仔猪,为了让猪增加采食量,喂猪时添加了食盐,连续用几天后。发现猪突然拒食,在圈内表现为转圈、兴奋不安,只喝水不[详细]
-
医:猪群排血痢,猪痢疾、猪增生性肠炎傻傻分不清...
猪痢疾和增生性肠炎都是猪场常见的疾病,都有排血痢的现象,可造成猪的饲料利用率降低,生长速度受阻,使猪的出栏可延迟10-15天,有的形成僵猪,如不及时对症治疗猪的死亡率可出现高死亡率的现象,给养殖业造成了不小的经济损失。一、猪血痢诊断要点1、各种年[详细]
-
医:母猪产仔少原因有哪些?受精卵死亡的三个时期一定注意下!
母猪通常排卵大约20—25枚,卵子的受精率可达95%以上。而母猪的产仔数多在9—13头之间,这说明有30%—40%的受精卵死亡,受精卵的死亡有三个时期。1:前期死亡:精子与卵子在输卵管的壶腹部受精形成的受精卵,受精卵呈游离状态,不断向子宫游动,到达子宫系膜[详细]